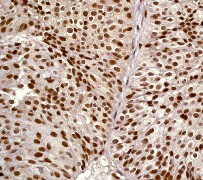

> Antigen, Antibodies, ELISA, Western Blot > Primary Antibody > Monoclonal Antibodies > RSK2 Antibody (C-term)Brand |
Leading Biology | Catalog Number |
AMM07681G |
Product Type |
Monoclonal Antibodies | Field of Research |
|
Product Overview |
We constantly strive to ensure we provide our customers with the best antibodies. As a result of this work we offer this antibody in purified format.
We are in the process of updating our datasheets. If you have any questions regarding this update, please feel free to contact our technical support team.
This product is a high quality RSK2 antibody (C-term).
|
||
Molecular Weight |
83736 Da
|
||
Cellular Localization |
Antigen Cellular Localization:
Nucleus. Cytoplasm
|
||
Host |
Rabbit
|
||
Species Reactivity |
Human, Rat
|
||
Target |
A synthetic peptide corresponding to residues in C-terminus of human p90-RSK2 was used as immunogen.
|
||
Clone |
Y82
|
||
Symbol |
ISPK1, MAPKAPK1B, RSK2
|
||
GeneID |
|||
UniProt ID |
|||
Function |
Serine/threonine-protein kinase that acts downstream of ERK (MAPK1/ERK2 and MAPK3/ERK1) signaling and mediates mitogenic and stress-induced activation of the transcription factors CREB1, ETV1/ER81 and NR4A1/NUR77, regulates translation through RPS6 and EIF4B phosphorylation, and mediates cellular proliferation, survival, and differentiation by modulating mTOR signaling and repressing pro-apoptotic function of BAD and DAPK1. In fibroblast, is required for EGF-stimulated phosphorylation of CREB1 and histone H3 at 'Ser-10', which results in the subsequent transcriptional activation of several immediate-early genes. In response to mitogenic stimulation (EGF and PMA), phosphorylates and activates NR4A1/NUR77 and ETV1/ER81 transcription factors and the cofactor CREBBP. Upon insulin-derived signal, acts indirectly on the transcription regulation of several genes by phosphorylating GSK3B at 'Ser-9' and inhibiting its activity. Phosphorylates RPS6 in response to serum or EGF via an mTOR- independent mechanism and promotes translation initiation by facilitating assembly of the preinitiation complex. In response to insulin, phosphorylates EIF4B, enhancing EIF4B affinity for the EIF3 complex and stimulating cap-dependent translation. Is involved in the mTOR nutrient-sensing pathway by directly phosphorylating TSC2 at 'Ser-1798', which potently inhibits TSC2 ability to suppress mTOR signaling, and mediates phosphorylation of RPTOR, which regulates mTORC1 activity and may promote rapamycin-sensitive signaling independently of the PI3K/AKT pathway. Mediates cell survival by phosphorylating the pro- apoptotic proteins BAD and DAPK1 and suppressing their pro- apoptotic function. Promotes the survival of hepatic stellate cells by phosphorylating CEBPB in response to the hepatotoxin carbon tetrachloride (CCl4). Is involved in cell cycle regulation by phosphorylating the CDK inhibitor CDKN1B, which promotes CDKN1B association with 14-3-3 proteins and prevents its translocation to the nucleus and inhibition of G1 progression. In LPS-stimulated dendritic cells, is involved in TLR4-induced macropinocytosis, and in myeloma cells, acts as effector of FGFR3-mediated transformation signaling, after direct phosphorylation at Tyr-529 by FGFR3. Phosphorylates DAPK1.
|
||
Summary |
RSK2 is a member of the family of 90-kDa ribosomal S6 kinases (1). These proteins are a class of serine/threonine kinases that are activated in response to various extracellular signals, including growth factors, polypeptide hormones and neurotransmitters (2). RSK2 phosphorylates a wide range of substrates, including ribosomal protein S6, and plays a significant role in mediating extracellular signal-related kinase (ERK) signal transduction. Mutations in RSK2 have been found to be associated with Coffin-Lowry syndrome (3).
|
||
Form |
50 mM Tris-Glycine (pH 7.4), 0.15 M NaCl, 40% Glycerol, 0.01% sodium azide and 0.05% BSA. |
||
Storage & Stability |
Store at +4°C short term. For long-term storage, aliquot and store at -20°C or below. Stable for 12 months at -20°C. Avoid repeated freeze-thaw cycles.
|
||
Applications |
WB, IHC
|
||
Dilution |
WB~~1:1000
IHC~~1:250~500
|
||
Synonyms |
Ribosomal protein S6 kinase alpha-3, S6K-alpha-3, 90 kDa ribosomal protein S6 kinase 3, p90-RSK 3, p90RSK3, Insulin-stimulated protein kinase 1, ISPK-1, MAP kinase-activated protein kinase 1b, MAPK-activated protein kinase 1b, MAPKAP kinase 1b, MAPKAPK-1b, Ribosomal S6 kinase 2, RSK-2, pp90RSK2, RPS6KA3, ISPK1, MAPKAPK1B, RSK2
|
||
Images |

A. Western blot analysis on MCF7 cell lysate using anti-Rsk2 (C-term) RabMAb (Cat. AMM07681G), dilution 1:1,000.
B. Immunohistochemical analysis of paraffin-embedded human urinary bladder carcinoma using anti-RSK2 (C-term) RabMAb (Cat. AMM07681G). |
||
Specification |
|||
Quantity |
|
||
| Select | Brand | Catalog No. | Product Name | Pack Size | Type | Field of Research | Specification | Quantity | Price(USD) | |
| 1 | Leading Biology | APG02467G | CCK4 / PTK7 Antibody (clone 4F9) | 50 μl | Monoclonal Antibodies |
|
$495.00 | Add Ask | ||
| 2 | Leading Biology | AMM04683G | GALT Antibody (clone 4C11) | 50 μg | Monoclonal Antibodies |
|
$545.00 | Add Ask | ||
| 3 | Leading Biology | AMM01402G | Vimentin (Mesenchymal Cell Marker) Antibody - With BSA and Azide | 50 ug | Monoclonal Antibodies |
|
$395.00 | Add Ask | ||
| 4 | Leading Biology | APR08280G | LTA4H / LTA4 Antibody (clone 9G8) | 50 μl | Monoclonal Antibodies |
|
$495.00 | Add Ask | ||
| 5 | Leading Biology | AMM00172G | CD1a / HTA1 (Mature Langerhans Cells Marker) Antibody - With BSA and Azide | 50 ug | Monoclonal Antibodies |
|
$395.00 | Add Ask | ||
| 6 | Leading Biology | AMM05750G | CEBPA Antibody | 100 μl | Monoclonal Antibodies |
|
$545.00 | Add Ask |
 Leading Biology Inc.
2600 Hilltop DR, Building G, B Suite C138
Richmond, CA, 94806
Tel: 1-661-524(LBI)-0262
Email: info@leadingbiology.com
Leading Biology Inc.
2600 Hilltop DR, Building G, B Suite C138
Richmond, CA, 94806
Tel: 1-661-524(LBI)-0262
Email: info@leadingbiology.com
Complete this form and click send to ask us a question, request a quote or simply say hello.

You have 0 item in your cart

You have 0 item in your inquiry list
